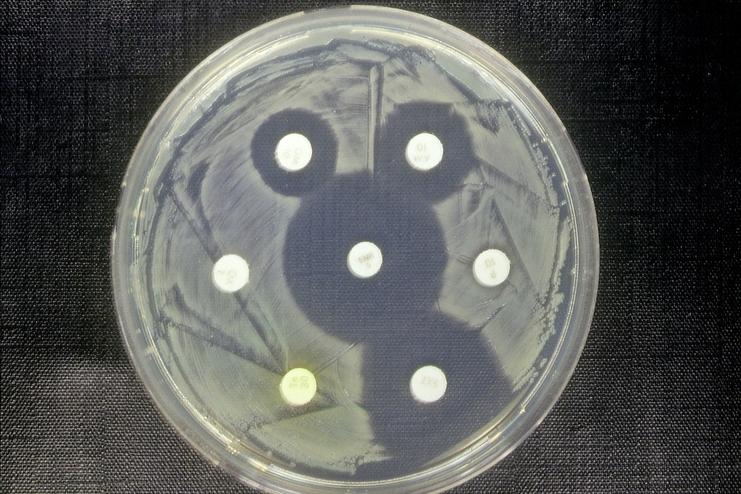

Rufen Sie uns an: +49 (0) 2551-78 78
NEWS
von der AVA und aus der Branche
Der Bundesverband für Tiergesundheit e. V. (BfT) und der Bun-desverband Rind und Schwein e. V. (BRS) präsentieren auf der Grünen Woche 2026 einen gemeinsamen Stand auf dem ErlebnisBauernhof (Halle 3.2, Stand 319).
Unter dem Motto „Nachhaltigkeit durch Tierwohl, Tiergesundheit und Zuchtfortschritt. Verantwortung für die Zukunft der Landwirtschaft“ laden die Verbände politische Entscheidungsträgerinnen und -träger, Vertreterinnen und Vertreter aus Wissenschaft und Verbänden sowie Besucherinnen und Besucher ein, über aktuelle Herausforderungen und Lösungen für eine zukunftsfähige Tierhaltung ins Gespräch zu kommen.
Gesunde Nutztiere sind die Grundlage für Tierwohl, nachhaltige Landwirtschaft und eine sichere Lebensmittelversorgung. Fortschritte in der Tiergesundheit sowie eine verantwortungsvolle Zucht führen zu robusten und widerstandsfähigen Tieren, die eine ressourcenschonende, effiziente und zukunftsfähige Tierhaltung ermöglichen.
Im Sinne des One-Health-Ansatzes leisten Tierzucht und Tiergesundheit damit auch einen Beitrag zur öffentlichen Gesundheit – denn gesunde Tiere bedeuten sichere Lebensmittel und gesunde Menschen. Der Auftritt von BfT und BRS zeigt, wie Innovation, Verantwortung und Nachhaltigkeit in der modernen Tierhaltung Hand in Hand gehen. Besucherinnen und Besucher erwartet ein interaktiver Treffpunkt, der zum Mitmachen und Diskutieren einlädt:
• Video-Screen mit anschaulichen Beispielen aus der Praxis zur modernen Tierhaltung
• „Tierischer Kicker“ – spielerisch ins Gespräch kommen
• Interaktives Quiz rund um Tierwohl, Tiergesundheit, Tierzucht und Nachhaltigkeit im Rahmen der Erlebnispfade
Mit ihrem Gemeinschaftsstand möchten BfT und BRS zeigen: Nachhaltigkeit beginnt mit robusten, gesunden Tieren. Fortschritte in Prävention, Management und Zucht bilden die Grundlage für eine Tierhaltung, die ökologische, ökonomische und gesellschaftliche Ziele miteinander verbindet – im Sinne einer zukunftsorientierten Agrarpolitik.
Bundesverband für Tiergesundheit e.V.
Dr. Sabine Schüller, Koblenzer Str. 121-123, 53177 Bonn,
Tel. 0228 / 31 82 96, E-Mail bft@bft-online.de , www.bft-online.de
Widerrufsbelehrung ohne Telefonnummer unwirksam?
Warum die vollständige Widerrufsbelehrung für Unternehmer und Verbraucher so entscheidend ist
Die Frage, ob eine Widerrufsbelehrung nur wirksam ist, wenn sie eine Telefonnummer enthält, beschäftigt seit geraumer Zeit Rechtsprechung und Literatur. Das OLG Brandenburg hat diese Frage nun eindeutig beantwortet und damit einen bedeutenden Akzent im Verbraucherrecht gesetzt. Die Entscheidung zeigt, wie streng die Anforderungen an Unternehmer sind, wenn sie Verbraucherverträge schließen, und wie weitreichend die Folgen eines scheinbar kleinen Fehlers sein können. Wir erleben in der täglichen Beratung, dass Widerrufsrechte oft unterschätzt werden, obwohl sie erhebliche wirtschaftliche Konsequenzen haben.
Fazit: Verbraucher eröffnet sich mit dieser Entscheidung der erhebliche Vorteil, dass Verträge auch nach Monaten widerrufbar sind, wenn z.B. die Telefonnummer fehlt… .
Uruguay will sich nicht einmischen – Schicksal von 3000 Rindern weiter unklar
Ein Schiff mit Rindern irrt seit 70 Tagen durchs Mittelmeer – das Ziel ist weiter unbekannt. Uruguay und die Türkei wollen sich «nicht in Geschäfte zwischen Privatpersonen einmischen».
Knapp 3000 Rinder sind seit über 70 Tagen auf einem Frachter aus Uruguay eingepfercht, weil ihnen im Zielhafen in der Türkei der Empfang verweigert wurde. Ein grosses globales Medienecho hat jetzt auch die Regierungen der beiden Länder dazu bewogen, sich zu dem Transport zu äussern. Die Zukunft der Tiere ist trotzdem weiterhin unklar.
Am 11. September verliess die Spiridon II den Hafen in Montevideo und nahm Kurs auf Bandirma in der Türkei. Doch bei seiner Ankunft am 22. Oktober verweigerten die türkischen Behörden dem Frachter die Entladegenehmigung. Grund: Unstimmigkeiten in den tierärztlichen Zertifikaten bei einem Teil der Fracht, berichtet die Taz.
«Eine kleine Gruppe von Tieren war vom Importeur nicht ausgewählt worden», wird Marcelo Rodríguez, Abteilungsleiter für Viehzucht im uruguayischen Agrarministerium, zitiert. Doch Uruguays Agrarminister Alfredo Fratti weist jede Verantwortung zurück. «Es handelt sich um eine Angelegenheit zwischen Privatpersonen. Wir haben wiederholt betont, dass sich die Regierung – zumindest in Uruguay – nicht in Geschäfte zwischen Privatpersonen einmischt. Die Verantwortung dafür liegt nicht bei uns.»... .
Vogelgrippe in Niedersachsen - Kritik an Massenkeulungen
Niedersachsens Tierschutzbeauftragte kritisiert den Umgang mit der Vogelgrippe. «Aus Sicht des Tierschutzes halte ich die Bekämpfung der Seuche für fragwürdig - und auch ethisch nicht mehr für vertretbar», sagte Julia Pfeiffer-Schlichting der «Nordwest-Zeitung»
«Das massenhafte Keulen von Tieren wird von der Gesellschaft nicht mehr akzeptiert.» Die Tierschutzbeauftragte wünscht sich mehr Prävention im Kampf gegen die Vogelgrippe. «Wo präventive Maßnahmen möglich sind, müssen sie auch Pflicht sein», fordert Pfeiffer-Schlichting. Noch vor Jahren sei die Seuche eher selten aufgetreten, inzwischen gebe es ganzjährig Ausbrüche.
Mehr als eine Million Tiere gekeult
Seit Jahresbeginn sind in Niedersachsen mehr als eine Million Tiere wegen der Vogelgrippe getötet worden. Betroffen sind dem Agrarministerium zufolge vor allem Hühner und Puten. Die Geflügelpest, auch Vogelgrippe genannt, ist eine bei vielen Vogel- und Geflügelarten häufig tödlich verlaufende Infektionskrankheit.
Der niedersächsische Landtag befasst sich heute mit der Ausbreitung der Seuche. Die CDU fordert ein entschlossenes Vorgehen: «Wenn die Regierung zaudert, leiden Tiere und Landwirtschaft», heißt es in ihrem Antrag. Die Grünen thematisieren die Lage der Großställe und wollen vor allem Prävention und Resilienz verbessern.
AVA-Kommentar:
Niedersachsens Tierschutzbeauftragte (seit Mai 2024) hält die Tierseuchenbekämpfung gegen die Vogelgripe aus Tierschutzgründen für "fragwürdig".
Die Tierschutzbeauftragte von NDS, Kollegin Julia Pfeiffer-Schlichting , entstammt einer TIerarztfamilie, ist /war Grünen-Stadträtin in Bad Bevensen und Mitgründerin des Vereins „Tierärzte für verantwortbare Landwirtschaft“. Dieser Verein fordert einen „Systemwechsel hin zu regionaler, naturerhaltender Landwirtschaft in bäuerlichen Strukturen“, insbesondere in der Nutztierhaltung.
Ihr Wechsel zu diesem Posten schien umstritten gewesen zu sein, wie die "taz" berichtete.
Ob sie sich in die Geflügelpestbekämpfung einmischen sollte, beurteilen Sie bitte selbst... .
Grippesaison Deutschland 2024/25 - aktuelle Fallzahlen
Die Grippesaison scheint Deutschland bereits ganz schön „im Griff“ zu haben. Wie die Situation der aktuellen Fallzahlen in Ihrem Heimatkreis aussieht, können Sie anhand einer Karte bei proplanta.de nachschauen.
Wenn Antibiotika versagen: Wo steht Deutschland?
Wenn Antibiotika nicht mehr wirken, ist das mitunter lebensgefährlich. In Deutschland gibt es für einige Antibiotikaresistenzen Zielvorgaben - die Entwicklung ist nach Daten des Robert Koch-Instituts (RKI) noch nicht überall auf einem guten Weg. Eine Übersicht zu den wichtigsten Fragen.
Wie entstehen Antibiotikaresistenzen?
Antibiotika zählen nach Einschätzung des Robert Koch-Instituts (RKI) zu den wichtigsten medizinischen Errungenschaften, doch die Resistenzen dagegen nähmen weltweit zu. «Sie sind eine der größten Herausforderungen für die globale Gesundheit dieser Zeit.»
Ein Bakterium kann laut RKI durch natürliche Veränderungen im Erbgut resistent gegen ein Antibiotikum werden oder durch die Aufnahme von Resistenzgenen, die von anderen Bakterien stammen. Die häufige Nutzung von Antibiotika in der weltweiten Medizin fördert resistente Bakterien: Solche, die eine Resistenz gegen ein Antibiotikum besitzen, überleben dessen Einsatz und können sich weiter ausbreiten. Wenn Antibiotika ohne einen triftigen Grund, zu oft, über einen zu langen Zeitraum oder unsachgemäß angewandt werden, begünstigt das die Entstehung und Verbreitung von resistenten Erregern, so das RKI.
Was macht Deutschland gegen die Resistenzen?
Im Kampf gegen die Resistenzen hatten verschiedene Ministerien etwa die Deutsche Antibiotikaresistenz-Strategie (DART 2030) aufgestellt. Einige Punkte: Mit Impfungen und besserer Hygiene sollen mehr Infektionen verhindert werden, so dass generell weniger Antibiotika nötig sind. Der Antibiotikaverbrauch bei Mensch und Tier soll besser überwacht und die Forschung gefördert werden.
Dabei wurden Ziele definiert, mit denen sich die Entwicklung bewerten lässt. Das RKI präsentierte nun eine Art Zwischenstand. So soll beispielsweise der Gesamtverbrauch von Antibiotika im stationären und ambulanten Bereich bis 2030 um 9 Prozent im Vergleich zu 2019 gesenkt werden. Er war jedoch 2024 leicht angestiegen.
Bei vier Erreger-Antibiotika-Kombinationen sollte die Zahl der sogenannten Blutstrominfektionen pro 100.000 Einwohner bis 2030 im Vergleich zu 1990 jeweils um einen gewissen Prozentsatz gesenkt werden. Bei der Infektion dringen Bakterien in den Blutkreislauf ein, was zu einer lebensbedrohlichen Sepsis führen kann. 2024 lagen demnach zwei Kombinationen im Zielbereich, die anderen zwei - an denen E. coli und Klebsiellen beteiligt sind - lagen deutlich schlechter.
Wie sieht es bei E. coli und einem Antibiotikum aus?
Eine der beobachteten Kombinationen ist E. coli mit Resistenz gegen die Antibiotikagruppe der Cephalosporine der dritten Generation. Das sei eine ganz wichtige Gruppe, betont Tim Eckmanns, RKI-Experte für Antibiotikaresistenzen. «Und E. coli ist der häufigste Erreger von Infektionen im Krankenhaus.»
Am Beispiel dieser Erreger-Antibiotika-Kombinationen zeige sich, wie unterschiedlich die Krankheitsbilder bei einer Infektion sein können. «Das ist das Schwierige an Antibiotikaresistenzen», erklärt er, «das ist nicht eine Krankheit, sondern dahinter verbergen sich viele Infektionen.» E. coli kann etwa einen Harnwegsinfekt, eine Wundinfektion oder eine Bauchrauminfektion verursachen.
Welche der vier Kombinationen ist die kritischste?
«Das kritischste würde ich sagen, sind die Carbapenem-Resistenzen von Klebsiellen», erklärte Eckmanns. Die Inzidenz von Blutstrominfektionen mit Carbapenem-resistenten Klebsiella pneumoniae soll bis 2030 um 2 Prozent im Vergleich zu 2019 reduziert werden. Allerdings steigen die Inzidenzen von Blutstrominfektionen seit 2020. Mit einer Zunahme um 65 Prozent seit 2019 lagen die Inzidenzen demnach weit schlechter als die Zielvorgaben.
Mit weniger als einem Fall pro 100.000 Einwohnern bleibt die Inzidenz laut RKI insgesamt gering. «Und trotzdem finde ich, ist das die kritischste, weil diese Infektionen sind dann auch wirklich nicht mehr leicht zu behandeln. Da haben wir nicht mehr viele Optionen», so Eckmanns. Klebsiella pneumoniae löst häufig Krankenhausinfektionen aus und kann zur Sepsis führen.
Wie viele Menschen sind in dem Zusammenhang gestorben?
Laut einer Studie eines Teams des RKI und der Universität Washington vom August 2025 starben im Jahr 2019 rund 45.700 Menschen in Deutschland im Zusammenhang mit antibiotikaresistenten Erregern. Nicht immer war dabei die Resistenz die direkte Ursache. Besonders häufig führten Blutstrominfektionen sowie Atemwegs- und Bauchrauminfektionen zum Tod. Rund 9.600 dieser Menschen sind laut RKI jedoch unmittelbar aufgrund der Resistenz des Erregers gestorben. Zum Vergleich: Die Gesamtzahl der 2019 in Deutschland verstorbenen Menschen lag laut Statistischem Bundesamt bei 939.500 Menschen.
Was kann man tun?
Um Antibiotikaresistenzen zu verringern, ist ein gezielter und sachgerechter Einsatz von Antibiotika wichtig. So sollte man Antibiotika nicht bei einer Virusinfektion, sondern nur bei bakteriellen Infektionen einnehmen, erläutert Eckmanns. Gegen Viren sind sie wirkungslos.
Außerdem sollten sie von Ärzten nur dann gegeben werden, wenn sie wirklich notwendig sind. Zudem: «Niemals ein Antibiotikum eigenständig einnehmen, weil man denkt "Ich habe ja hier noch eins liegen"», erklärte der Experte. Der Einnahme müsse immer eine Untersuchung vorangegangen sein.
Überdies helfe alles, was Infektionen verringere. «Eine geimpfte Bevölkerung ist eine gute Maßnahme gegen Resistenzentwicklung.» Je weniger Antibiotika genutzt werden, desto weniger Resistenzen gebe es.
------------------
Lesen Sie zum Thema auch den interessanten Beitrag vom 21.11.2025 in "tiermedizin.thieme.de" mit dem Titel: Umwelteinflüsse von Antibiotika
Antibiotikarückstände in der Umwelt sind ein Problem – und die Erforschung dessen steht noch ganz am Anfang. Doch welche Konsequenzen ergeben sich daraus für die Tiermedizin?
Geplatzte Vion-Übernahme: Tönnies will Kaufvertrag lösen
Die Premium Food Group hat nach der Entscheidung des Bundeskartellamts, den geplanten Kauf mehrerer Vion-Standorte zu untersagen , nun ein überraschendes Angebot unterbreitet.
|
Auf welchen Luxus Reiche 2026 Wert legen
Der weltweite Luxusmarkt schrumpft. Im laufenden Jahr werden voraussichtlich 1,44 Billionen Euro für teure Autos, edles Essen, Jachten, Privatjets und ähnliches ausgegeben, wie eine Studie der Unternehmensberatung Bain & Company und des italienischen Luxusgüterverbands Fondazione Altagamma prognostiziert.
| ||||
Aviäre Influenza (Vogelgrippe): Fast alle Landkreise in Rheinland-Pfalz betroffen
Immer mehr Tiere in Rheinland-Pfalz sind mit der Vogelgrippe infiziert.
|
Tierschützer besorgt: Horror-Frachter mit tausenden Rindern vom Radar verschwunden (mit Video)
Das Viehtransportschiff "Spiridon II" war auf dem Weg nach Uruguay. Doch im Mittelmeer ist das Signal verloren gegangen. Der Verdacht besteht, dass Tierkadaver oder Gülle illegal entsorgt wurden.
Vor zwei Monaten stach das Boot Spiridon II in See. Doch der Frachter wurde von der Türkei abgelehnt und befand sich auf dem Rückweg nach Montevideo, so zeigt der Schiffsverfolgungsdienst MarineTraffic.
Der Transporter sendet seit mehreren Tagen kein Ortungssignal mehr. Auf der "Spiridon II" befanden sich über 3.000 Rinder. Diese harrten auf der langen Anreise mehrere Wochen vor der türkischen Küste aus. Das ausgeschaltete Signal deutet auf eine illegale Entsorgung von Tierkadavern oder Gülle hin.
"Tiere stehen seit Monaten in ihren eigenen Exkrementen"
Gegenüber der "dpa" erklärte die deutsche Tierschutzorganisation Animal Welfare Foundation: "Wenn das Schiff wirklich wie angegeben nach Uruguay zurückkehrt, gehen wir davon aus, dass das Schiff leer ankommen wird." Laut ihnen sei die Situation auf dem Schiff katastrophal: "Die Tiere stehen seit Monaten in ihren eigenen Exkrementen und besonders in den unteren Etagen ist die Ammoniakbelastung extrem hoch.".. .
Siehe auch HIER die Meldung vom 19.11.2025
